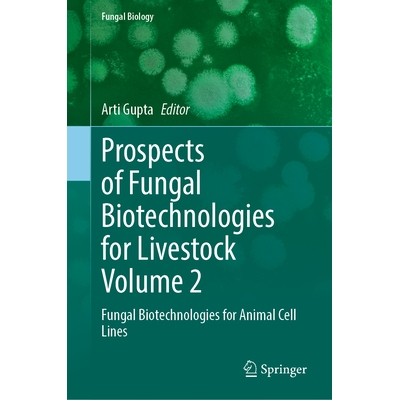

Animal 2 优惠券折扣
商品筛选
-
 书籍/杂志/报纸
10.69
折扣
书籍/杂志/报纸
10.69
折扣
14.5正版畅销书 动物庄园animal farm(英文原版书+中文译本) 全套2册中英文对照书籍 英汉双语译林读物名著书籍原著初高中大学英语阅读
天猫好物 博库旗舰店
购买 -
 模玩/动漫/周边/娃圈三坑/桌游
39
低价
模玩/动漫/周边/娃圈三坑/桌游
39
低价
Animal Bakery Series动物烘焙坊系列2盲盒潮玩公仔摆件手办礼物
天猫好物 sonnyangel旗舰店
购买 -
 11月下旬到货
51.4
券后价
11月下旬到货
51.4
券后价
64预售 苹果树动物事务所2 The Appletree Animal Agency Collie Chaos 英文原版 儿童文学 黑白插图章节小说故事书 进口 又日新
销量2 又日新图书专营店
3元优惠券 -
 英汉双语译林读物 初高中大学生课外英语阅
12.7
折扣
英汉双语译林读物 初高中大学生课外英语阅
12.7
折扣
14.5正版畅销书 动物庄园animal farm(英文原版书+中文译本) 全套2册
销量66 天猫超市
购买 -
![【2-3周达】Cute Animals That Could Kill You Dead: An Adorable and Deadly Animal Facts Book for Kids [9781464236594]](https://img.alicdn.com/bao/uploaded/i4/2107887916/O1CN01bXhyoP28LaJkhykRO_!!4611686018427384108-0-item_pic.jpg) 书籍/杂志/报纸
86
官方立减
书籍/杂志/报纸
86
官方立减
102【2-3周达】Cute Animals That Could Kill You Dead: An Adorable and Deadly Animal Facts Book for Kids [9781464236594]
销量3 澜瑞图书专营店
优惠16元 -
 书籍/杂志/报纸
91
券后价
书籍/杂志/报纸
91
券后价
113动物救援局2册 惊险救援+穿山甲营救档案 The Animal Rescue Agency 英文原版 儿童文学故事 黑白插图章节小说 又日新
销量5 又日新图书专营店
5元优惠券 -
 书籍/杂志/报纸
119
券后价
书籍/杂志/报纸
119
券后价
147国家地理儿童动物百科全书第2版 英文原版 National Geographic Kids Animal Encyclopedia 2nd edition 精装儿童科普图画书籍
销量20 优学宝贝图书专营店
5元优惠券 -
 玩具/童车/益智/积木/模型
26.88
官方立减
玩具/童车/益智/积木/模型
26.88
官方立减
31.682pcs Animal Snowball Maker Kids Toys Plastic Clip Children P
淘宝好物 迷雾一去不回头
优惠4.8元 -
 书籍/杂志/报纸
229
券后价
书籍/杂志/报纸
229
券后价
335Step into Reading 兰登阅读进阶2 动物兄弟系列10册套装 Wild Animal 英文原版进口 儿童文学 分级阅读读本童书
销量5 又日新图书专营店
55元优惠券 -
 书籍/杂志/报纸
52.2
券后价
书籍/杂志/报纸
52.2
券后价
65可可西瓜动物舞会 CoComelon Animal Dance! 英文原版 儿童纸板书 绘本图画书 进口儿童读物 低幼亲子童书 2-5岁 又日新
销量6 又日新图书专营店
3元优惠券 -
![【2-3周达】Everyone's Included at the Animal Party: The Little Boy Learns About Feelings, Inclusion, ... [9798330243167]](https://img.alicdn.com/bao/uploaded/i1/2107887916/O1CN01yYQSGn28LaLOPonip_!!4611686018427384108-0-item_pic.jpg) 书籍/杂志/报纸
164
官方立减
书籍/杂志/报纸
164
官方立减
194【2-3周达】Everyone's Included at the Animal Party: The Little Boy Learns About Feelings, Inclusion, ... [9798330243167]
天猫好物 澜瑞图书专营店
优惠30元 -
 商务/设计服务
3.23
官方立减
商务/设计服务
3.23
官方立减
3.8Animal Hyperrealism vol2 野兽/鸟类动物叫声音效库
淘宝好物 VFX设计素材
优惠0.57元 -
![【2-3周达】The Prince and a Magical Squishy Animal Birthday: Funny Fantasy Children's Picture Book Wi... [9798988416524]](https://img.alicdn.com/bao/uploaded/i1/2107887916/O1CN01xLL1MO28LaLIW7Kwj_!!4611686018427384108-0-item_pic.jpg) 书籍/杂志/报纸
230
官方立减
书籍/杂志/报纸
230
官方立减
271【2-3周达】The Prince and a Magical Squishy Animal Birthday: Funny Fantasy Children's Picture Book Wi... [9798988416524]
天猫好物 澜瑞图书专营店
优惠41元 -
 书籍/杂志/报纸
51
官方立减
书籍/杂志/报纸
51
官方立减
60可可西瓜动物舞会 CoComelon Animal Dance! 英文原版 儿童纸板书 绘本图画书 进口儿童读物 低幼亲子童书 2-5岁【中商原版】
销量5 中华商务图书专营店
优惠9元 -
 服饰配件/皮带/帽子/围巾
710
单品直降
服饰配件/皮带/帽子/围巾
710
单品直降
10601h可退 COACH 女士帽子 29CCL500TN2 AW2025 浅棕色 Animal motif
天猫好物 天猫国际探物中国香港
优惠191元 -
 服饰配件/皮带/帽子/围巾
710
单品直降
服饰配件/皮带/帽子/围巾
710
单品直降
10601h可退 COACH 女士帽子 29CCL500TN2 AW2025 浅棕色 Animal motif
天猫好物 天猫国际探物中国香港
优惠191元 -
 保健食品/膳食营养补充食品
375.7
满件折
保健食品/膳食营养补充食品
375.7
满件折
470.21Animal,分离乳清蛋白质粉,曲奇奶油味,2 磅(907 克)
天猫好物 iHerb营养海外旗舰店
优惠23.51元 -
![【2-3周达】A Dog Takes a Bite Out of Alzheimer's: Connections: Animal Assisted Therapy For Alzheimer'... [9780999376102]](https://img.alicdn.com/bao/uploaded/i1/2107887916/O1CN01fWuvBl28LaL81iNSW_!!4611686018427384108-0-item_pic.jpg) 书籍/杂志/报纸
217
官方立减
书籍/杂志/报纸
217
官方立减
256【2-3周达】A Dog Takes a Bite Out of Alzheimer's: Connections: Animal Assisted Therapy For Alzheimer'... [9780999376102]
天猫好物 澜瑞图书专营店
优惠39元 -
 书籍/杂志/报纸
18.7
官方立减
书籍/杂志/报纸
18.7
官方立减
22动物单词卡片 2-4 岁 海洋昆虫爬行哺乳动物 学前幼儿园 Carson Dellosa Animal Flash Cards 美国CarsonDellosa 大音
销量1 大音图书音像专营店
优惠3.3元 -
Fungal Biotechnologies for Animal Cell L
1753
券后价
Fungal Biotechnologies for Animal Cell L
1753
券后价
2298预订 Prospects of Fungal Biotechnologies for Livestock Volume 2: Fungal Biotechnologies for Animal Cell Lines 畜牧真菌生
天猫好物 中国国际图书专营店
200元优惠券 -
 书籍/杂志/报纸
142
官方立减
书籍/杂志/报纸
142
官方立减
168动物大百科英文原版儿童科普绘本2册套装 动物的野生生活The Wild Life Of Animals 动物也有好朋友Animal BFFs【中商原版】
销量4 中华商务图书专营店
优惠26元 -
 书籍/杂志/报纸
35.7
官方立减
书籍/杂志/报纸
35.7
官方立减
42Animal Pants 动物裤子 英文原版进口图书 低幼早教 儿童绘本 幽默趣味 押韵故事图画书 2-5岁
天猫好物 大音图书音像专营店
优惠6.3元 -
 商务/设计服务
1.43
满件折
商务/设计服务
1.43
满件折
1.51150 【英文】Knitted Wild Animal Friends 棒针编织玩偶图解
销量2 太阳花手作素材2
优惠0.07元 -
 玩具/童车/益智/积木/模型
13.59
折扣
玩具/童车/益智/积木/模型
13.59
折扣
14.32pcs Black Cat Nail Stickers 3D Cute Cartoon Animal 3D Self-
淘宝好物 Beauty Makeup Store1
购买 -
 玩具/童车/益智/积木/模型
52.6
官方立减
玩具/童车/益智/积木/模型
52.6
官方立减
61.9Christmas Highland Cow Calendar Advent 2D Acrylic Animal Orn
淘宝好物 迷雾一去不回头
优惠9.3元 -
 玩具/童车/益智/积木/模型
43.26
折扣
玩具/童车/益智/积木/模型
43.26
折扣
48.072pcs Stardew Valley Chicken Pillow Plush Soft Stuffed Animal
淘宝好物 Hipster Store
购买 -
 玩具/童车/益智/积木/模型
207
官方立减
玩具/童车/益智/积木/模型
207
官方立减
244正品LEGO乐高45009 得宝幸运动物游戏套装 Animal Bingo适合2-5岁
淘宝好物 乐一高一号店
优惠37元 -
 童装/婴儿装/亲子装
291
单品直降
童装/婴儿装/亲子装
291
单品直降
346日本直邮Kladskap Animal 2way连体服
天猫好物 天猫国际全球探物
优惠3元 -
 童装/婴儿装/亲子装
291
单品直降
童装/婴儿装/亲子装
291
单品直降
346日本直邮Kladskap Animal 2way连体服
天猫好物 天猫国际探物日本
优惠3元 -
![【3-4周达】Tears of an Animal 2: Tragedy and Chaos [9781736110638]](https://img.alicdn.com/bao/uploaded/i4/2107887916/O1CN015Tawfu28LaLDFtMYw_!!4611686018427384108-0-item_pic.jpg) 书籍/杂志/报纸
154
官方立减
书籍/杂志/报纸
154
官方立减
182【3-4周达】Tears of an Animal 2: Tragedy and Chaos [9781736110638]
天猫好物 澜瑞图书专营店
优惠28元